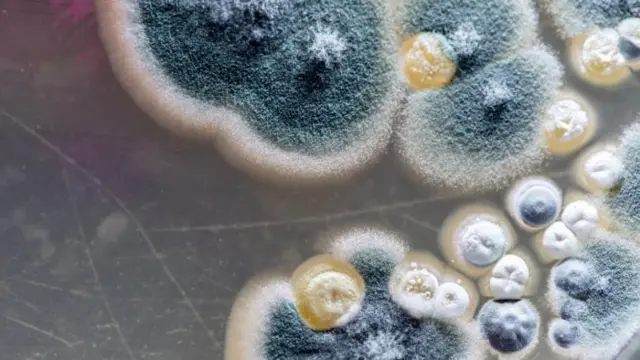

Mece ce ruma?
Asalin hoton, Getty Images
Ruma wani yanayi ne da ake samu na rayuwar ‘yan kananan halittu (da ake kira da Ingilishi fungi) a wurin da ake da danshi ko kuma yake da makwabtaka ko kusanci da ruwa.
Wadannan 'yan kananan halittu wadanda ido ba ya iya ganinsu, suna rayuwa ne a galibi inda yake da kusanci da raba ko ruwa musamman inda iska ba ta shiga ta fita, sannan kuma hasken rana ba ya ratsawa, in ji masana.
Wannan yanayi inda wadannan ‚yan mitsimitsin halittu ke rayuwa shi ne suke rubar da abubuwa da ake iya gani ya jikin bango ko litattafai ko tufafi, inda za a ji har daki ko wurin da kayan suke yake wari.
Me ke janyo ruma?
Haka kuma za a iya cewa ruma danshi ne a killataccen wuri da zai iya kasancewa daki ne ko wata akwatu ko wani wurin ajiye abu, inda sakamakon yanayi musamman na damuna ya kansa danshi da yake cikin iska ya haifar da wannan ruma.
Lokacin damuna shi ne lokacin da aka fi samun danshi a cikin iska, wannan ne ya sa a lokacin aka fi samun ruma.
Sannan kusancn wuri da ruwa ko da ba a lokacin damuna ba ne, misali idan daki ko gini yana kusa da inda ruwa yake ana samun ruma a wurin.
Kamar magudanar ruwa ko famfo ya fashe ko wata rijiya ko kuma wurin da aka yi ginin wuri ne mai dausayi, duka wadannan suna kara haddasa ruwa, muddin babu iska wadatacciya da hasken rana a wannan killataccen wuri.
Illar ruma ga lafiyar mutum
Ruma tana haifar da illoli da dama kama daga na muhalli zuwa ga kayayyaki da ma lafiyar mutane.
Yanzu za ku iya samun labaran BBC Hausa kai-tsaye a wayoyinku.
Latsa nan domin shiga
Karshen Whatsapp
A bangaren lafiya ruma tana da illa musamman ga mutanen da suke da kan-jiki domin ta kan janyo wasu mutanen masu irin wannan larura jikinsu ya rika kaikayi har ma kuraje su fito a jikinsu, kamar yadda Dakta Ibrahim Mijinyawa, wani likita a Abuja ya yi wa BBC bayani.
Likitan ya ce, yanayin yana kuma iya shafar ido ta yadda za a ga idanuwan mutum na yin ja sannan ga kaikayi da ruwa,.
Wanda wannan duk matsala ce da ruma ko wannan danshi na damuna ko wurin da ruwa ke kwanciya ko makwabtaka ke yi ga lafiyar jikin mutum.
Haka kuma likitan ya ce akwai mutanen da wannan ruma ko danshi ke sa wa suna mura kusan kodayaushe a lokacin damuna ko kuma idan suka shake shi.
Sannan yanayin yakan iya tsananta wa wasu mutamnen da ke da larurar numfashi musamman asma ko mura ko kuma tari.
Likitan ya ce ga masu irin wannan matsala ta numfashi, hanyar da suke shakar numfashi ka iya toshewa, wanda idan ba a yi sauri na ba su magani ba, matsalar ka iya kai su ga rasa rai.
Illa ga gini da kayayyaki
Ruma tana illa ga gini sosai ta yadda take cin bangon daki ko gini wanda a kwana a tashi idan ba a yi hattara ba takan rage wa gini kwari har ma ta kai a wayi gari ya zube.
Wannan kamar yadda bayani ya kasance a baya, wadannan halittu ‚yan kanana da ke rayuwa a cikin danshi su ke haddasa wannan.
Harwayau ruwa ko danshi na illa ga tufafi ko takardu, inda wadannan mitsimitsin halittu da ke cikinta ke rubar da irin wadannan abubuwa kamar yadda suke yi wa duk wani kaya da suka tattaru a kai a sanadiyyar wannan yanayi na lema ko ruwa, idan har ba iska da ke ratsa wurin da kuma hasken rana.
A takaice wannan wuri ya zama tamkar gida ne na irin wadannan halittu na su kama wuri su zauna domin rayuwarsu kamar yadda mu ma mutane ko dabbobi manya mukan wanzu a muhallin da ya dace da mu.
Hanyoyin kariya daga ruma
Akwai hanyoyi da dama na kare kai da muhalli wadanda dan-Adam zai iya amfani da su domin raba kansa da wannan matsala kamar yadda Farfesa Aliyu Barau malami a sashen tsara birane da yankuna na Jami’ar Bayero da ke Kano, wanda ya yi wa BBC bayani kan wannan matsala da kuma yadda za a iya neman kariya daga gareta.
Kasancewar rashin shiga da fitar iska a wuri na daga cikin abubuwan da ke haifar da ruma da danshi, malamin ya ce baya ga neman shawarar kwararru idan za a yi gini.
Ya ce akwai bukatar a yi gini ta yadda iska za ta rika shiga tana fita a daki, ta yadda zai kasance idan iska ta shigo daga misali gabas za ta fita ta yamma ko kuma wani bangare na daban na daki.
Sannan yana da kyau a tabbatar ruwa ba ya kwanciya a kusa da daki ko gini ta yadda wannan danshi zai rika shafar ginin.
Masanin ya ce yana da kyau idan aka yi gini a wurin da yake da danshi a yi masa jingina ko kewaye shi da duwatsu kamar yadda maginan Hausa kan kira irin wannan kariya "dan-tofi’’.
Ya ce idan aka yi wa gini irin wannan dauri yakan hana raba ratsa dutsen har ta kai ga ainahin ginin ta janyo ruwa da za ta yi wa gini illa.
Kariyar lafiya
A bagaren lafiya kuwa masana na nuna cewa yana da kyau a lokacin damuna mutane su rika bude kofa da taga iska na shiga tana fita, hasken rana ma na shiga.
Mutanen da suke da larurar numfashi misali asma, ya kamata lokacin su rika takatsantsan kada ruma ta yi musu yawa a gida, wadanda suke da babbar darduma ko kafet a daki ko gida yana da kyau su nade shi domin yana bayar da dama ruma ko danshi ya zauna, har su rika tayar musu da matsalar.
Harwayau mutumin da yake da matsalar ta numfashi ya kamata a lokacin damuna idan yana amfani da bargo wurin kwanciya sai ya daina ya rika amfani da mayafi na yadi, amma ba abin da yake da gashi ba, domin bargo saboda gashi yana tayar da matsalar asma.
Amfani da tafarnuwa
A al’adance wasu kan yi amfani da tafarnuwa ko albasa a wawwatsa a daki ko wurin da ake samun ruma a lokacin damina wanda hakan kan sa danshi ya ragu saboda tasirin musamman ita tafarnuwar, wadda tana tsotse danshi.
Amfanin ruma
Idan akwai wani amfani ga ruma watakila za a iya cewa shi ne samar da taki ta yadda take rubar da ita ce ko tsirrai ko kuma wani abu da zai iya zama taki, wanda hakan ba karamin amfani ba ne ga manoma.











